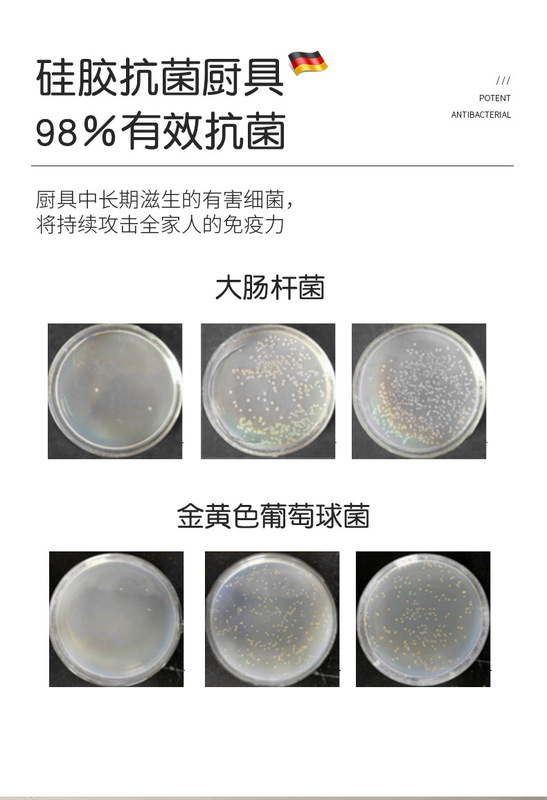

- SPU: AL-O5SL-8ryvufmg[F8]
- Product Category: Cooking Spatula
- Material: silicone
- Printing LOGO: Yes
- Processing and customization: Yes
- Product launch time: 2022
- Price range: 5-10 yuan
- Whether there is a patent: None
- Style: modern minimalist
- Copyright: None
- Function: non-stick pan
- Function: anti-slip
- Function: high temperature resistance
- Function: anti-scalding
- Handle material: beech

After sales information
Within 15 days from the date of receipt, customers can be provided with an unconditional return service. The application for return of goods requires the consent of the merchant in the store.
Procurement and delivery
Delivery time: For products in stock, they will be shipped within 3 working days (excluding holidays) after you place your order and make payment. You will receive our notification after shipment.
payment
Credit card payment (quick payment) is a new payment method jointly launched by third-party payment platforms and major banks. It is one of the safest and easiest payment methods. Users do not need to activate online banking in advance, they can complete quick payments by entering information such as card face and mobile phone dynamic password. Quick payment allows various bank card users to conveniently make online payments without the need for special online banking activation.
No data available